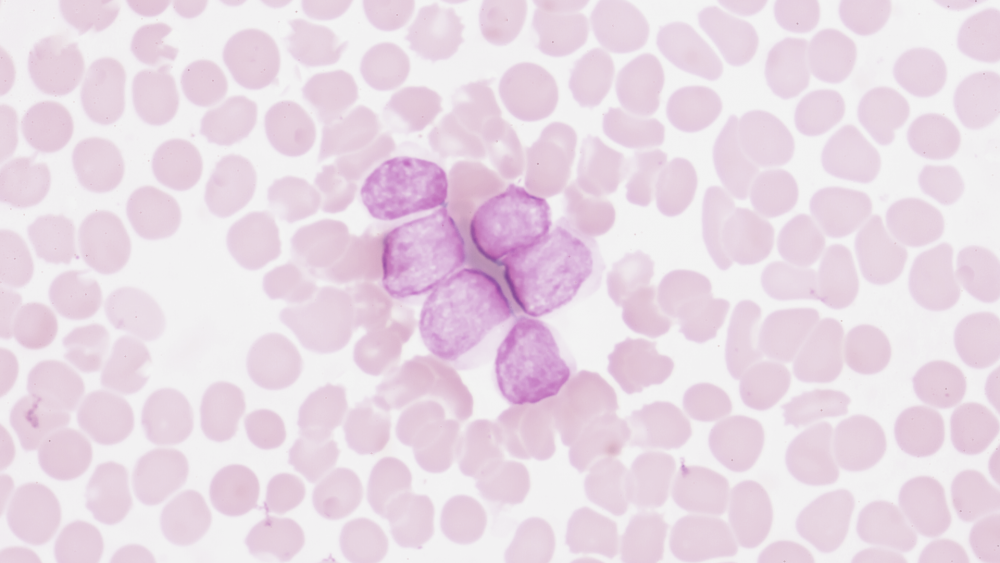

Рак гортани
Злокачественные опухоли гортани находятся на 5 месте по частоте заболеваемости в России.

Рак пищевода
Рак пищевода (РП) — опухоль злокачественного характера, образующаяся из эпителиальных клеток пищевода.

Саркомы мягких тканей головы и шеи
Саркома мягких тканей (СМТ) — это злокачественное новообразование, развивающееся из клеток внескелетной соединительной ткани, к которой относятся все анатомические образования между скелетом и кожей: мышцы, жировая ткань, сухожилия, связки и т. д.).

Рак губы
Рак губы — злокачественное новообразование, образованное из клеток многослойного плоского эпителия в зоне красной каймы губ.

Опухоли средостения и сердца
Опухоли средостения бывают как злокачественными, так и доброкачественными. Их выявляют в основном в среднем и молодом возрасте. Опухоли сердца в качестве первичного очага встречаются очень редко и в 75–80% случаев являются доброкачественными.

Метастазы злокачественных опухолей без выявленного первичного очага
В некоторых случаях онкологическое заболевание проявляется в виде метастатических опухолей, тогда как первичный очаг выявить невозможно.

Рак желчных протоков
Рак желчных протоков (РЖП) — злокачественное новообразование из слизистых оболочек желчных протоков, причем любой их части. Оно может расти как внутри печени, так и за пределами органа.

Плоскоклеточный рак анального канала
Плоскоклеточный рак анального канала (ПРАК) — редкий вид онкологических заболеваний, в этой зоне локализуются до 2% всех опухолей толстой кишки.

Карцинома Меркеля
Карцинома Меркеля — это агрессивный вид рака кожи. Обычно она выглядит как болезненный узелок телесного, красно-фиолетового или розового цвета.

Адренокортикальный рак
Адренокортикальный рак (АКР) — редкое онкозаболевание, при котором опухоль образуется в корковом слое надпочечника. Это агрессивный вид злокачественного образования, характеризующийся поздним сроком выявления.

Трофобластические опухоли
Трофобластические опухоли — это опухоли, появление которых всегда связано с беременностью. Они образуются из трофобластов — клеток, которые образуют внешний слой эмбриона и участвуют в его прикреплении к стенке матке, а также в образовании плаценты.

Острые лейкозы
Острые лейкозы развиваются стремительно, в крови человека за короткий срок концентрируется большое количество атипичных клеток.
Хронические лейкозы
Это клональное опухолевое новообразование, которое обусловлено злокачественным перерождением ранних гемопоэтических (кроветворных) клеток и характеризуется постепенным распространением и разрастанием атипичных клеток.

Лимфома Ходжкина
Лимфома — это злокачественное заболевание лимфатической системы, при котором происходит увеличение лимфатических узлов и появление очагов во внутренних органах, зачастую не относящихся к лимфатической системе, из-за того что в них накапливаются опухолевые лимфоциты.

Неходжкинские лимфомы
Неходжкинские лимфомы (НХЛ), в противоположность лимфоме Ходжкина, часто расположены вне лимфатических узлов и склонны к метастазированию, редко ограничиваются одной областью, поражая часто костный мозг и печень.

Рак шейки матки
Рак шейки матки (РШМ) — один из наиболее распространенных видов рака. В России каждый пятый случай рака приходится на РШМ.

Увеальная меланома
Увеальная меланома (УМ) — это злокачественная опухоль сосудистой оболочки, образованная из мутировавших меланоцитов (пигментных клеток) глаза.

Гастроинтестинальные стромальные опухоли
Гастроинтестинальные стромальные опухоли (ГИСО) развиваются из клеток соединительной ткани, относятся к группе сарком. ГИСО могут развиться в стенках пищеварительного тракта (от пищевода и до ануса), но чаще всего локализованы в желудке или тонкой кишке.

Рак желудка
Рак желудка — злокачественная опухоль, которая образуется из клеток слизистой органа.

Рак легкого
Данный вид онкозаболеваний представлен злокачественным новообразованием желез и слизистой оболочки легочной ткани и бронхов.

Рак толстой (ободочной) кишки
Рак ободочной кишки (РОК) — одно из самых распространенных онкологических заболеваний. Оно занимает третье место среди всех злокачественных образований системы пищеварения.

Рак предстательной железы
Рак предстательный железы (РПЖ) развивается из ее эпителиальных клеток. Это заболевание прогрессирует сравнительно медленно. Среди мужского населения России данный вид рака по распространенности занимает второе место после рака легкого.

Меланома кожи
Меланома кожи — агрессивное злокачественное новообразование, развивающееся из перерождающихся меланобластов и меланоцитов (производят меланин, отвечают за способность к загару и образование родинок).

Рак кожи: базалиома
Рак кожи — собирательное название для злокачественных новообразований, сформировавшихся из трансформировавшихся клеток кожи. К раку кожи относятся различные виды заболеваний, основные из них — базальноклеточная карцинома и сквамозноклеточная карцинома.

Рак молочной железы
Рак молочной железы (РМЖ) — одно из самых распространенных онкологических заболеваний в мире. Оно известно еще с древности. Ранее болезнь считалась неизлечимой и всегда приводила к летальному исходу. Однако в XXI веке лечение рака не является чем-то необычным или невозможным.
{{ arConvalescenceHistoryPost.title }}
{{ arConvalescenceHistoryPost.excerpt }}

